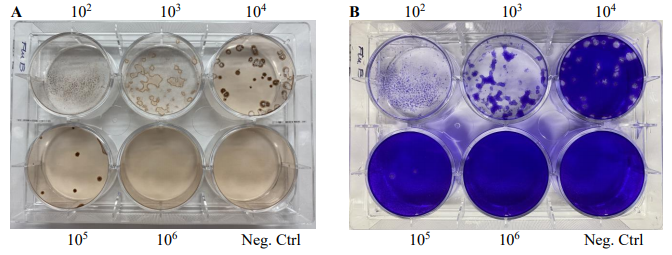
VPK-5190.jpg

PRODUCT CENTER
特色產(chǎn)品當(dāng)前位置:首頁 > 特色產(chǎn)品
流感病毒是一種包膜病毒,主要根據(jù)內(nèi)部核蛋白(NP)的保守性抗原差異分為甲型(A)、乙型(B)和丙型(C)三種類型。其中,只有甲型和乙型流感病毒對人類具有臨床相關(guān)性。
在細(xì)胞單層中進(jìn)行的噬斑測定是定量檢測感染性病毒和抗病毒物質(zhì)的最常用方法。在這些測定中,每個感染性病毒顆粒在特定條件下繁殖,形成一個局部感染細(xì)胞區(qū)域,稱為噬斑。噬斑表現(xiàn)為死亡或破壞的細(xì)胞區(qū)域,可通過通用細(xì)胞染色檢測到。
Cell Biolabs的流感B型免疫噬斑測定試劑盒提供了一個準(zhǔn)確的系統(tǒng),用于測定病毒的感染性滴度。與傳統(tǒng)的噬斑測定不同,該試劑盒使用特異性的抗流感B型核蛋白抗體進(jìn)行免疫染色,以揭示感染細(xì)胞區(qū)域的噬斑。試劑盒提供的試劑足以在12孔板中進(jìn)行最多60次滴定實(shí)驗(yàn)。
作為Cell Biolabs全國總代理,艾美捷科技強(qiáng)烈推薦Cell Biolabs熱銷產(chǎn)品乙型流感免疫空斑檢測試劑盒。產(chǎn)品僅用于科研,不可用于臨床診斷。
| 產(chǎn)品名稱 | 貨號 | 詳情 |
| 乙型流感免疫空斑檢測試劑盒 | VPK-5190 | 查看 |
乙型流感免疫空斑檢測試劑盒檢測原理:
第一天:在12孔或6孔板中接種MDCK細(xì)胞
↓
第二天:用流感病毒系列稀釋液感染MDCK細(xì)胞,并添加覆蓋培養(yǎng)基
↓
第五天:用抗流感病毒核蛋白抗體進(jìn)行染色
↓
計(jì)數(shù)陽性噬斑并計(jì)算病毒滴度
相關(guān)產(chǎn)品
1. VPK-5170:RSV融合蛋白ELISA試劑盒
2. VPK-5171:RSV核蛋白ELISA試劑盒
3. VPK-5174:流感A型核蛋白ELISA試劑盒
4. VPK-5175:流感B型核蛋白ELISA試劑盒
5. VPK-5189:流感A型免疫噬斑測定試劑盒
試劑盒組成(常溫運(yùn)輸)
1. 5倍DMEM培養(yǎng)基(部件號51901B):一瓶30毫升無菌瓶,含有5倍DMEM、碳酸氫鈉、非必需氨基酸和5毫克/毫升BSA。
2. CytoSelect?瓊脂粉(部件號113001):一瓶1.2克。
3. TPCK-胰蛋白酶(100倍)(部件號51902C):一瓶1毫升無菌管,含有100微克/毫升TPCK-胰蛋白酶和1毫克/毫升BSA。
4. 抗流感B型核蛋白抗體(1000倍)(部件號51903C):一瓶30微升。
5. 辣根過氧化物酶標(biāo)記二抗(1000倍)(部件號10902):一瓶50微升。
6. DAB底物(25倍)(部件號10903):一瓶1.5毫升。
7. 稀釋液(10倍)(部件號10905):一瓶4.5毫升。
未提供材料
1. 流感B型病毒樣本
2. MDCK細(xì)胞、細(xì)胞培養(yǎng)生長培養(yǎng)基和無菌DPBS
3. 無菌細(xì)胞培養(yǎng)級水
4. 微波爐或加熱塊
5. 水浴鍋
6. 10%中性緩沖甲醛
7. 0.1% Triton X-100的PBS溶液
8. 1% BSA/PBS溶液
9. H?O?
10. 顯微鏡
保存方法
收到試劑盒后,將TPCK-胰蛋白酶、抗流感B型核蛋白抗體和二抗保存在-20℃。其他所有試劑盒組分保存在4℃。
結(jié)果示例
以下圖表展示了典型的滴定結(jié)果。以下數(shù)據(jù)僅供參考,不應(yīng)用于解釋實(shí)際結(jié)果。
圖:流感B型病毒在MDCK細(xì)胞中的免疫噬斑測定滴定實(shí)驗(yàn)
使用不同稀釋度的流感B型病毒培養(yǎng)液感染MDCK細(xì)胞72小時。進(jìn)行了抗流感B型核蛋白免疫染色(A)和結(jié)晶紫染色(B)。
圖1:流感A型病毒感染MDCK細(xì)胞的噬斑形成
流感A型病毒用于感染MDCK細(xì)胞24至72小時。感染后24小時、48小時和72小時,按照檢測協(xié)議進(jìn)行抗流感A型核蛋白免疫染色。
文獻(xiàn)參考:
1. Herz C, Stavnezer E, Krug R, Gurney T. (1981) Influenza virus, an RNA virus, synthesizes its messenger RNA in the nucleus of infected cells. Cell 26, 391–400.
2. Jackson DA, Caton AJ, McCready SJ, Cook PR. (1982) Influenza virus RNA is synthesized at fixed sites in the nucleus. Nature 296, 366–368.
3. Baer, A. & Kehn-Hall, K. (2014) Viral concentration determination through plaque assays: using traditional and novel overlay systems. J. Vis. Exp. 93, 52065.
Cell Biolabs公司位于美國加利福尼亞州南部重要的工業(yè)城市圣迭戈(San Diego),是有名的細(xì)胞學(xué)試劑品牌,作為前沿的細(xì)胞學(xué)分析檢測試劑盒生產(chǎn)商,為生物技術(shù)和研究類客戶提供好的基于細(xì)胞功能研究以及疾病等方面的高端產(chǎn)品和技術(shù)服務(wù)。產(chǎn)品主要涵蓋細(xì)胞研究、細(xì)胞信號通路和蛋白質(zhì)生物學(xué)、代謝研究、病原體和毒素、干細(xì)胞研究等領(lǐng)域。全球眾多大學(xué)、政府研究機(jī)構(gòu)、生物、制藥企業(yè)的科研實(shí)驗(yàn)室均在使用Cell Biolabs的產(chǎn)品。

微信掃碼在線客服